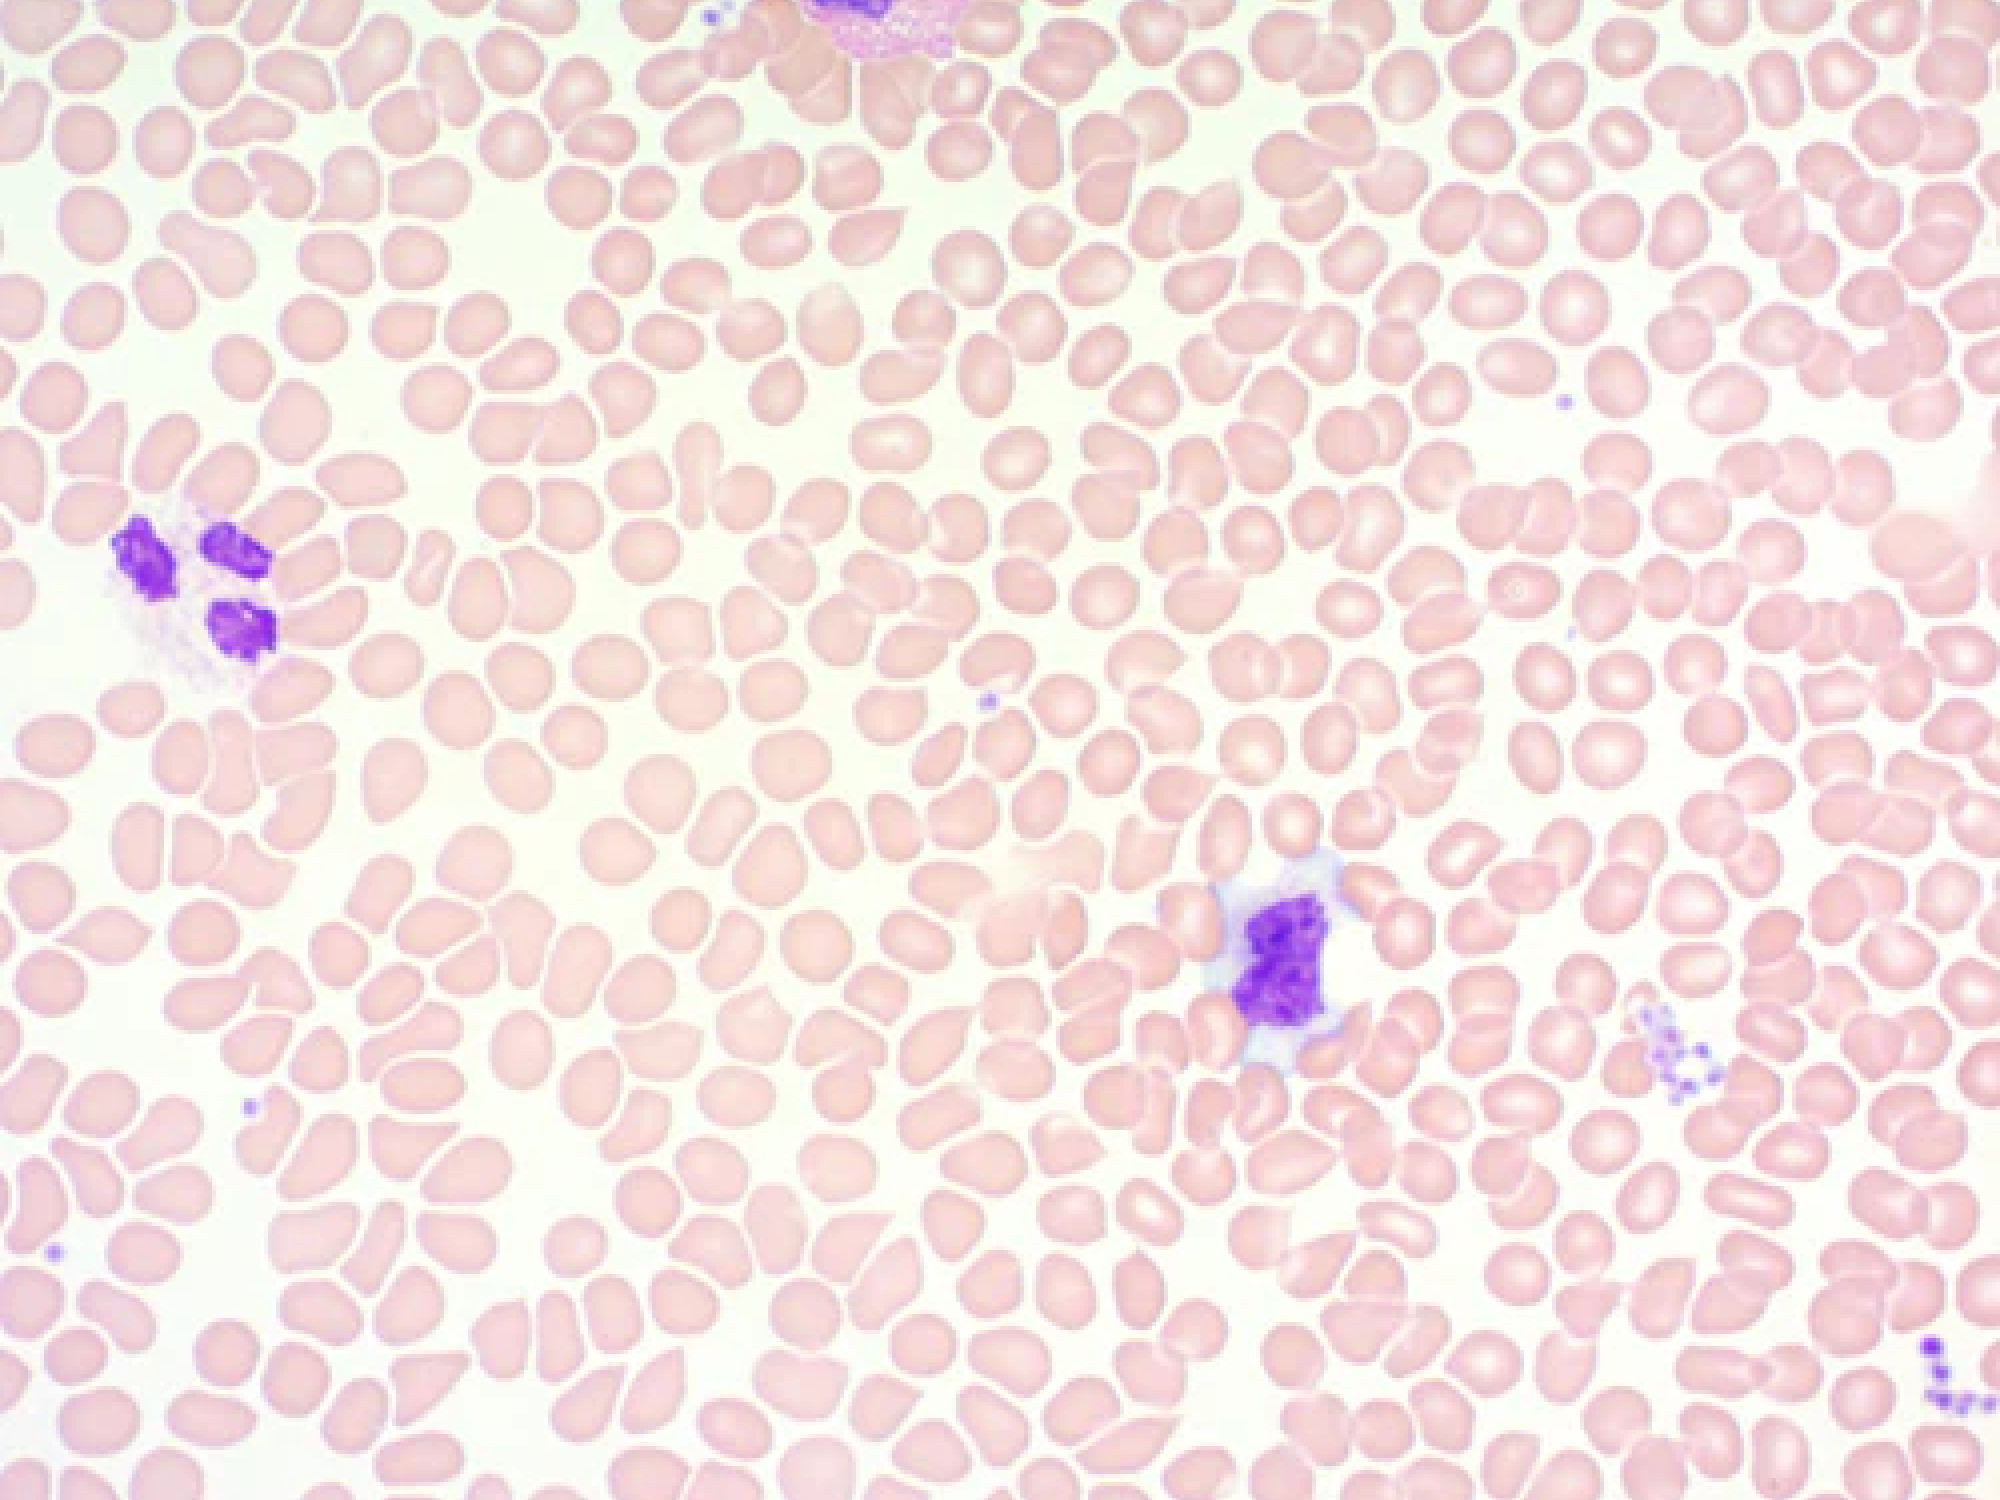
Wright-Giemsa Stain Kit

Special Stains
Orcein Stain Kit (For Hepatitis B and Elastic Fibers)
Sale priceFrom $151.19
Papanicolaou (PAP) Stain Kit
Sale priceFrom $54.00
Periodic Acid Schiff (PAS) Diastase Stain Kit
Sale priceFrom $114.17
Periodic Acid Schiff (PAS) for Fungus Stain Kit
Sale priceFrom $67.86
Periodic Acid Schiff (PAS) Stain Kit
Sale priceFrom $70.97
Periodic Acid Schiff (PAS) with Light Green Stain Kit
Sale priceFrom $85.45
Picro-Sirius Red Stain Kit (For Cardiac Muscle)
Sale price$72.50
Picro-Sirius Red Stain Kit (For Collagen)
Sale priceFrom $37.03
Pneumocystis Stain Kit
Sale priceFrom $84.84
Reticulum Stain Kit
Sale priceFrom $132.69
Reticulum Stain Kit (Modified Gomori's)
Sale priceFrom $129.60
Trichrome Stain Kit (Modified Gomori's)
Sale priceFrom $68.80
Trichrome Stain Kit (Modified Masson's)
Sale priceFrom $80.23
Trichrome Stain Kit (with Iodine)
Sale priceFrom $72.18